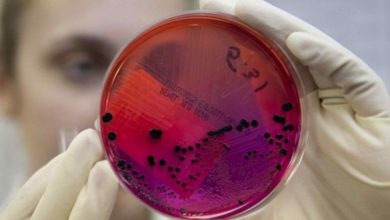

Денсаулық
-

«Қазақстан» телеарнасының 24 қызметкерінен коронавирус табылды
«Қазақстан» ТРК-де коронавирус инфекциясының 24 жағдайы тіркелді. «Қазақстан» телерадиокешені мен «Атамекен» ұлттық кәсіпкерлер палатасының қызметкерлері коронавирус жұқтырды. Бұл туралы Алматы…
-

Шымкентте карантин мерзімі ұзартылды
Оған 7 күн ішінде коронавирус инфекциясының 3,7 пайызға өскені себеп. Шымкенттің бас мемлекеттік санитарлық дәрігері Әбдіманап Төлебаев карантиндік және шектеу…
-

Үндістанда коронавирус жұқтыру дерегі Италиядан асып түсті
Үндістан коронавирусты жұқтырған саны бойынша Италиядан басып озып, әлем елдерінің арасында алтыншы орынға шықты. Елде расталған деректер саны 247 мыңнан…
-

ДДСҰ маскаларға қатысты ұстанымын өзгертті
Дүниежүзілік денсаулық сақтау ұйымы қоғамдық орындарда қорғаныс маскаларын тағуға қатысты ұсынымын жаңартты, деп хабарлайды «Хабар 24». Мамандар дүкен, қоғамдық көлік секілді…
-

Митингілер ауру жұқтыруға себепші болса, ұйымдастырушылар жазаланады – Бекшин
Алматының бас санитар дәрігері Жандарбек Бекшин Алматыдағы коронавирус жағдайына қатысты мәлімдеме жасады, – деп хабарлайды Tengrinews.kz тілшісі. Бекшиннің айтуынша, қалада коронавирус індеті…
-

Жапония коронавирустың емін тапты
Қытай билігі тұмау вирусының жаңа штаммдарына қарсы жапониялық дәрінің сынақ түрінде емдеу барысында коронавирустық инфекцияның жеңіл формасына ұшыраған науқастарды емдеуде…
-

Қазақстандық дәрігерлер тегін интернет және байланыспен қамтамасыз етіледі
Қазақстан аумағында жұмыс істейтін ұялы байланыс операторлары медицина қызметкерлерін тегін байланыспен қамтамасыз етуде, деп хабарлайды ҚазАқпарат ҚР Денсаулық сақтау министрлігіне…
-

Елордада қоғамдық орындар дезинфекцияланып жатыр
Әскери қызметшілер елордадағы қоғамдық орындарды дезинфекциялауда, деп хабарлайды ҚазАқпарат тілшісі. «Нұр-Сұлтан қаласы дезинфекциялау бойынша 7 секторға бөлінген. Әр секторда дезинфекция…
-
Қазақстанда COVID-19 вирусына қарсы вакцина дайындалып жатыр
Білім және ғылым министрлігінің тапсырмасы бойынша Ұлттық биотехнология орталығы мен Биологиялық қауіпсіздік проблемаларының ғылыми-зерттеу институты бірлесіп, COVID-19 коронавирусына қарсы вакцина…
